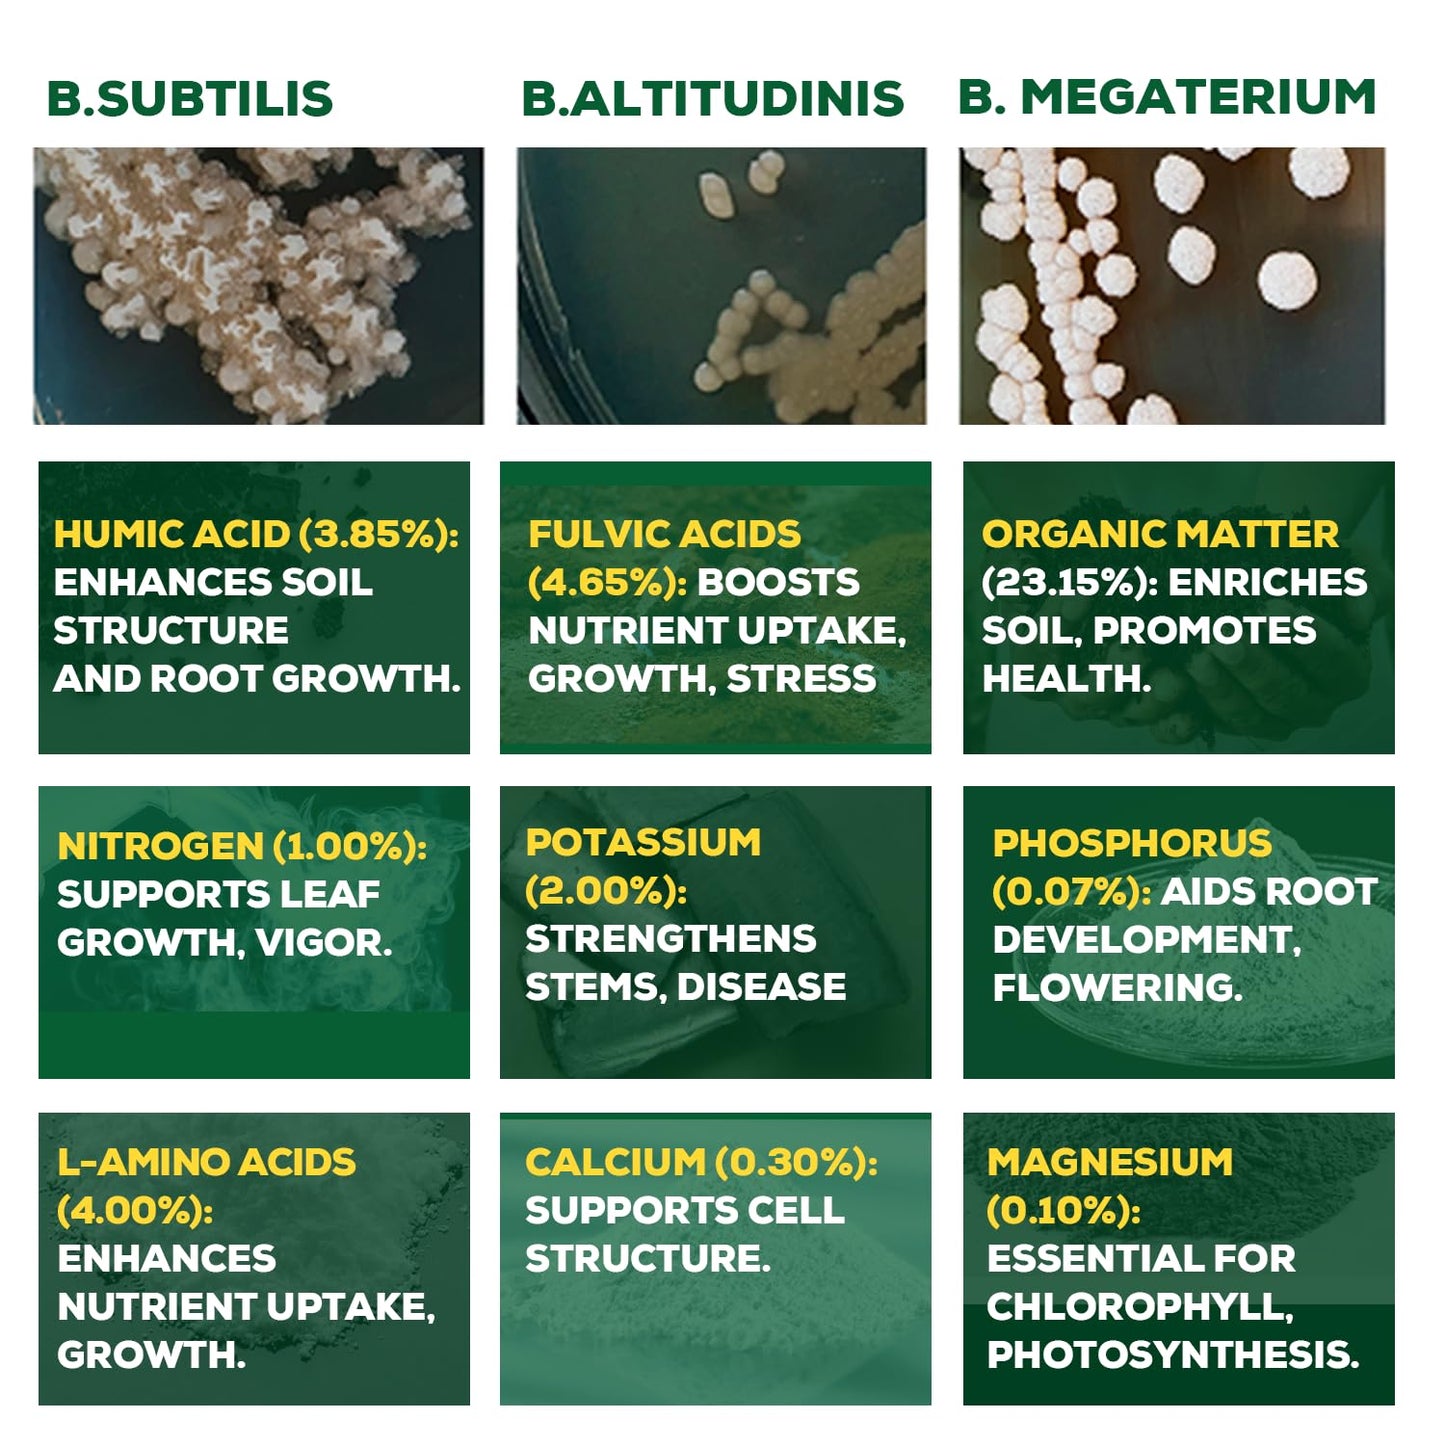
Organic Liquid Plant Food for Indoor Plants & Gardens, Natural NPK Fertilizer w/Beneficial Microbes, Rapid Results, Vegan, Best Value Super Concentrate, Smart Grower, Makes 40 Gallons (8 Fl Oz)

1
/
of
6
SmartGrower
Organic Liquid Plant Food for Indoor Plants & Gardens, Natural NPK Fertilizer w/Beneficial Microbes, Rapid Results, Vegan, Best Value Super Concentrate, Smart Grower, Makes 40 Gallons (8 Fl Oz)
Organic Liquid Plant Food for Indoor Plants & Gardens, Natural NPK Fertilizer w/Beneficial Microbes, Rapid Results, Vegan, Best Value Super Concentrate, Smart Grower, Makes 40 Gallons (8 Fl Oz)
Regular price
$26.92 USD
Regular price
$26.92 USD
Sale price
Unit price
/
per
Shipping calculated at checkout.
Couldn't load pickup availability
Overview
- Brand : Smart Grower
- Item Form : Liquid
- Coverage : 40 Gallons
- Liquid Volume : 8 Fluid Ounces
- Mixing ratio : 1:160
About this item
- Makes 40 Gallons of Fertlizer: Just 1/2 Tablespoon Per GALLON of water to ensure a safe and effective nourishment method for bigger healthier indoor plants. It's ideal for indoor plant food and plant food for houseplants, providing essential nutrients for healthy growth. This product is a best value super concentrate.
- No Bad Smell For Stronger Bigger Healthier Plants: Smart Grower Liquid Plant Food for indoor plants is a blend of natural nutrients without toxic chemicals that does not have an unpleasant smell like other fertlizers. There is no manure or fish emulsion in this fertlizer making it crulety free and vegan.
- Designed for Indoor and Container Plants: This liquid plant food serves as an effective indoor plant fertilizer and flower food, enhancing foliage and blooms for monstera plant live and many other varieties of flowers, fruits, vegetables, houseplants.
- Balanced NPK, Beneficial Microbes and Fulvic: Enriched with a balanced NPK of 1.1.2. and beneficial microbes, this liquid fertilizer for indoor plants supports soil health and nutrient absorption, making it a superior choice for indoor house plant and container fertilizer needs.
- Vegan and Cruelty-Free: Our house plant fertilizer is vegan and cruelty-free, committed to ethical plant nutrition. It's suitable for monstera plants and ensures a guilt-free approach to plant care, aligning with your values of sustainability.
Share